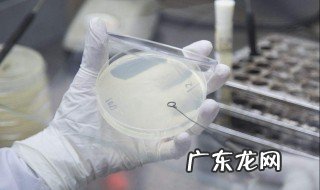

文章插图
1、硝化菌分为亚硝酸菌和硝酸菌,这两种都是好氧菌,和鱼一样,它们的生存必须消耗水里的氧气 。
2、硝化菌最适宜的温度是25度,这正是大多数热带鱼的生存温度 。
3、硝化作用从5度~35度都可以进行,在25度是最适宜的,所以不要认为冬天硝化菌就不工作了,它们只是活性降低而已 。
4、硝化菌不喜光,如果有条件最好制造全黑的环境,这不是必需条件,有最好,实在没有也行 。
【鱼缸如何培养硝化细菌 如何培养硝化细菌】5、硝化菌会形成菌膜,会吸附在固体表面进行繁衍,所以在鱼缸里我们需要为硝化菌提供足够的栖息场所 。
- 苹果横屏关闭在哪里设置 苹果横屏如何关闭
- 如何画出京剧猫小青的形象?
- 如何设置电信换光猫?
- 如何自制手举牌的方法 手举牌的制作方法
- 如何快速绑平结 如何绑简单的结
- 腾讯文档如何设置二次密码 腾讯文档能设置密码吗
- 如何清炒香菇 怎样清炒香菇好吃
- 如何设置铃声时间 如何设置铃声
- 微信公众号如何转载文章 微信公众号如何转载别人的文章
- 如何消除夫妻之间的隔阂 如何消除夫妻隔阂
特别声明:本站内容均来自网友提供或互联网,仅供参考,请勿用于商业和其他非法用途。如果侵犯了您的权益请与我们联系,我们将在24小时内删除。
